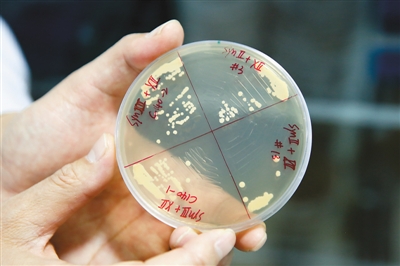
rmrbhwb2017031102p31_b rmrbhwb2017031102p31_b

首页>寻医·问药>医药科技医药科技
中国科学家合成完整活性染色体
图为3月9日,清华大学生命科学学院戴俊彪博士在展示培养皿中的酿酒酵母菌株。
新华社记者 沈伯韩摄
中国科学家利用化学物质合成了4条人工设计的酿酒酵母染色体,标志着人类向“再造生命”又迈进一大步。研究结果10日以封面文章的形式在国际知名学术期刊《科学》发表,中国也成为继美国之后第二个具备真核基因组设计与构建能力的国家。
来自天津大学、清华大学和深圳华大基因研究院的研究人员介绍,该研究利用小分子核苷酸精准合成了活体真核染色体,首次实现人工基因组合成序列与设计序列的完全匹配,所得到的酵母基因组具备完整的生命活性。
“如果说基因组测序是‘读懂生命密码’,基因组合成就是在‘编写生命密码’,从读到写,是一个巨大飞跃?!敝泄蒲г涸菏垦罨烂魉怠?/p>
2010年,美国科学家首次将人工合成的基因组植入一个原核细菌,开启了化学合成生命的研究大门。天津大学化工学院教授元英进告诉记者,原核生物基因组虽已合成成功,但其染色体相对简单,动物、植物、真菌等真核生物具有多条线性染色体,生命形式更复杂丰富,我国科学家在此次研究中解决了一系列科学难题。
研究中,基因组实际序列与设计序列的精确匹配至关重要。清华大学生命科学学院研究员戴俊彪说,研究人员创建了基因组缺陷靶点快速定位与精确修复方法,确?;Ш铣傻幕蜃榫哂懈叨鹊纳钚?。
酿酒酵母是生物遗传学研究的一个重要模式生物。以合成型酿酒酵母染色体为研究对象,可以加快在基因组重排、环形染色体进化领域的研究进度,为人类环形染色体疾病、癌症和衰老等提供研究与治疗模型。
2012年开始,天津大学、清华大学和深圳华大基因研究院与美国等国家的科研机构共同推动了酵母基因组合成国际计划(Sc2.0),旨在对酿酒酵母基因组进行人工重新设计和化学再造。我国科学家此次成功合成的4条酿酒酵母染色体,占Sc2.0计划已经合成染色体的2/3。(记者陈芳、董瑞丰)
编辑:赵彦
关键词:中国科学家 合成完 整活性染色体


中国制造助力孟加拉国首条河底隧道项目
澳大利亚猪肉产业协会官员看好进博会机遇
联合国官员说叙利亚约1170万人需要人道主义援助
伊朗外长扎里夫宣布辞职
中国南极中山站迎来建站30周年
联合国特使赴也门斡旋荷台达撤军事宜
以色列前能源部长因从事间谍活动被判11年监禁
故宫博物院建院94年来首开夜场举办“灯会”
法蒂玛·马合木提
王召明
王霞
辜胜阻
聂震宁
钱学明
孟青录
郭晋云
许进
李健
覺醒法師
吕凤鼎
贺铿
金曼
黄维义
关牧村
陈华
陈景秋
秦百兰
张自立
郭松海
李兰
房兴耀
池慧
柳斌杰
曹义孙
毛新宇
詹国枢
朱永新
张晓梅
焦加良
张连起
龙墨
王名
何水法
李延生
巩汉林
李胜素
施杰
王亚非
艾克拜尔·米吉提
姚爱兴
贾宝兰
谢卫
汤素兰
黄信阳
张其成
潘鲁生
冯丹藜
艾克拜尔·米吉提
袁熙坤
毛新宇
学诚法师
宗立成
梁凤仪
施 杰
张晓梅


